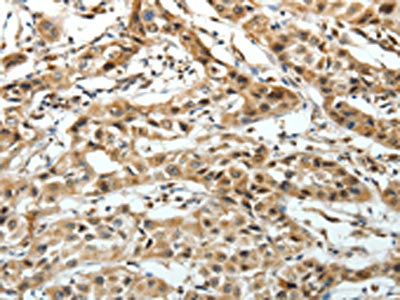

FZD3 Antibody
-
中文名稱:FZD3兔多克隆抗體
-
貨號:CSB-PA129862
-
規(guī)格:¥1100
-
圖片:
-
The image on the left is immunohistochemistry of paraffin-embedded Human lung cancer tissue using CSB-PA129862(FZD3 Antibody) at dilution 1/20, on the right is treated with synthetic peptide. (Original magnification: ×200)
-
The image on the left is immunohistochemistry of paraffin-embedded Human ovarian cancer tissue using CSB-PA129862(FZD3 Antibody) at dilution 1/20, on the right is treated with synthetic peptide. (Original magnification: ×200)
-
-
其他:
產(chǎn)品詳情
-
Uniprot No.:
-
基因名:
-
別名:FZD3; Frizzled-3; Fz-3; hFz3
-
宿主:Rabbit
-
反應(yīng)種屬:Human,Mouse
-
免疫原:Synthetic peptide of Human FZD3
-
免疫原種屬:Homo sapiens (Human)
-
標(biāo)記方式:Non-conjugated
-
抗體亞型:IgG
-
純化方式:Antigen affinity purification
-
濃度:It differs from different batches. Please contact us to confirm it.
-
保存緩沖液:-20°C, pH7.4 PBS, 0.05% NaN3, 40% Glycerol
-
產(chǎn)品提供形式:Liquid
-
應(yīng)用范圍:ELISA,IHC
-
推薦稀釋比:
Application Recommended Dilution ELISA 1:1000-1:5000 IHC 1:25-1:100 -
Protocols:
-
儲存條件:Upon receipt, store at -20°C or -80°C. Avoid repeated freeze.
-
貨期:Basically, we can dispatch the products out in 1-3 working days after receiving your orders. Delivery time maybe differs from different purchasing way or location, please kindly consult your local distributors for specific delivery time.
-
用途:For Research Use Only. Not for use in diagnostic or therapeutic procedures.
相關(guān)產(chǎn)品
靶點詳情
-
功能:Receptor for Wnt proteins. Most of frizzled receptors are coupled to the beta-catenin canonical signaling pathway, which leads to the activation of disheveled proteins, inhibition of GSK-3 kinase, nuclear accumulation of beta-catenin and activation of Wnt target genes. A second signaling pathway involving PKC and calcium fluxes has been seen for some family members, but it is not yet clear if it represents a distinct pathway or if it can be integrated in the canonical pathway, as PKC seems to be required for Wnt-mediated inactivation of GSK-3 kinase. Both pathways seem to involve interactions with G-proteins. Activation by Wnt5A stimulates PKC activity via a G-protein-dependent mechanism. Involved in transduction and intercellular transmission of polarity information during tissue morphogenesis and/or in differentiated tissues. Plays a role in controlling early axon growth and guidance processes necessary for the formation of a subset of central and peripheral major fiber tracts. Required for the development of major fiber tracts in the central nervous system, including: the anterior commissure, the corpus callosum, the thalamocortical, corticothalamic and nigrostriatal tracts, the corticospinal tract, the fasciculus retroflexus, the mammillothalamic tract, the medial lemniscus, and ascending fiber tracts from the spinal cord to the brain. In the peripheral nervous system, controls axon growth in distinct populations of cranial and spinal motor neurons, including the facial branchimotor nerve, the hypoglossal nerve, the phrenic nerve, and motor nerves innervating dorsal limbs. Involved in the migration of cranial neural crest cells. May also be implicated in the transmission of sensory information from the trunk and limbs to the brain. Controls commissural sensory axons guidance after midline crossing along the anterior-posterior axis in the developing spinal cord in a Wnt-dependent signaling pathway. Together with FZD6, is involved in the neural tube closure and plays a role in the regulation of the establishment of planar cell polarity (PCP), particularly in the orientation of asymmetric bundles of stereocilia on the apical faces of a subset of auditory and vestibular sensory cells located in the inner ear. Promotes neurogenesis by maintaining sympathetic neuroblasts within the cell cycle in a beta-catenin-dependent manner.
-
基因功能參考文獻:
- This study identified Circular RNA circ-CBFB as a sponge of miR-607, which targeted FZD3. PMID: 29902450
- schizophrenia may be related to some polymorphisms of gene FZD3 that are in stronger linkage disequilibrium to Chinese than to the other populations studied (Meta-Analysis) PMID: 27755292
- marked reduction in the prominence of TUJ1 bundles in number, thickness, and length. Our results showed that deregulation of the planar cell polarity genes CELSR3 and FZD3 might disrupt the enteric innervation pattern PMID: 27619161
- seven-transmembrane domain receptors Celsr3 and Fzd3, in particular, control the development of most longitudinal tracts in the central nervous system. [Review] PMID: 25813877
- Our analysis showed no significant association between the rs2241802 polymorphism in FZD3 gene and neural tube defects PMID: 24816679
- DNA methylation aberrations rather than polymorphisms of FZD3 gene increase the risk of spina bifida in a high-risk region for neural tube defects. PMID: 25131656
- Wnt3a/Frizzled-3 signaling plays important role in regulating the proliferation and differentiation of neural crest cells and various developmental stages of melanocyte precursors. PMID: 24815018
- Aberrant methylation modification of the FZD3 gene increases the risk of congenital hydrocephalus by altering chromatin structure and disturbing gene expression. PMID: 24796881
- FZD3 signaling sensitized peripheral sensory neurons in pain hypersensitivity. PMID: 24991956
- clinical significance of frizzled homolog 3 protein in colorectal cancer patients PMID: 24255701
- Genetic variants of the FZD3 gene may affect susceptibility to schizophrenia in Chinese Han and Va populations. PMID: 22027177
- This study found a significant association between schizophrenia and the FZD3 gene in single nucleotide polymorphisms and haplotype analyses. PMID: 14642436
- Results suggested that the FZD3 gene might be involved in the predisposition to schizophrenia. PMID: 15274031
- The FZD3 gene does not play a role in conferring susceptibility to schizophrenia variants in a Japanese sample. PMID: 15657645
- In German patients, neither single markers nor haplotypes in FZD3 were associated with schizophrenia. Further exploratory analyses using a different diagnostic approach did also not yield significant results. PMID: 17982906
- Fzd3 is expressed in Ewing sarcoma family tumor cell lines. Fzd3 mediated Wnt-3a-dependent neurite outgrowth. PMID: 18212053
顯示更多
收起更多
-
亞細胞定位:Membrane; Multi-pass membrane protein. Cell membrane; Multi-pass membrane protein. Cell surface. Apical cell membrane; Multi-pass membrane protein.
-
蛋白家族:G-protein coupled receptor Fz/Smo family
-
組織特異性:Widely expressed. Relatively high expression in the CNS, including regions of the limbic system, in kidney, pancreas, skeletal muscle, uterus and testis.
-
數(shù)據(jù)庫鏈接:
Most popular with customers
-
-
YWHAB Recombinant Monoclonal Antibody
Applications: ELISA, WB, IHC, IF, FC
Species Reactivity: Human, Mouse, Rat
-
Phospho-YAP1 (S127) Recombinant Monoclonal Antibody
Applications: ELISA, WB, IHC
Species Reactivity: Human
-
-
-
-
-